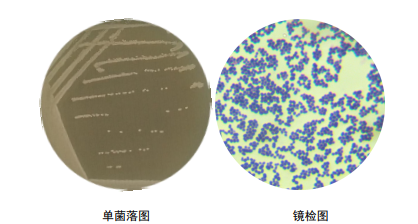
产品细节图片4

相关产品推荐更多 >
万千商家帮你免费找货
0 人在求购买到急需产品
- 详细信息
- 文献和实验
- 技术资料
- 库存:
100
- 英文名:
Enterococcus faecalis
- 保质期:
6年
- 供应商:
优利科(上海)生命科学有限公司
- 保存条件:
2-8℃
- 规格:
冻干粉
粪肠球菌菌种简介:
| 菌种名称 |
粪肠球菌 |
| 规格 |
冻干粉 |
| 生长条件 |
37℃;18-24小时;好氧 |
| 菌种主要应用 |
研究;分析检测。 |
粪肠球菌大小:1-2mm形状:圆形边缘:整齐透明度:不透明 颜色:灰白色 隆起度:中间凸起 表面:光滑明亮 质地:湿润易挑起,G+(蓝紫色),球菌,纯度:纯
保存条件:2-8℃
安瓿管开封步骤:


粪肠球菌传代方法:①准备1支含有5~10mL液体培养基的试管和2个平板;②安全柜中打开,用酒精灯灼烧顶部,后迅速滴上无菌水使之破裂,随后用镊子将其敲碎;③吸取0.5mL液体培养基打入冻干管,充分溶解后重新打回液体试管中,混匀;④吸取0.2mL菌悬液打入平板中,涂布均匀,重复两次获得两个平板;⑤将液体试管和平板全部置于上述培养条件下培养,菌种长出即可使用。
脑心浸液培养基(BHIA/BHIB):脑浸粉 5.0g,心浸粉12.5g,蛋白胨 5.0g,胰蛋白胨 10.0g,氯化钠 5.0g,葡萄糖 2.0g,磷酸氢二钠 2.5g,琼脂 20.0g(液体培养基不含),pH 7.4±0.2。121℃,15min灭菌。

复苏质量记录图片:
粪肠球菌相关产品:
| 慢葡萄球菌 | 模式菌株 |
| 马葡萄球菌 | |
| 鸡葡萄球菌 | |
| 小牛葡萄球菌 | 模式菌株 |
| 嵴链球菌 | 模式菌株 |
| 产氨棒杆菌 | |
| 山羊葡萄球菌 | 模式菌株 |
| 类产碱假单胞菌 | |
| 动物溃疡伯杰氏菌 | 模式菌株 |
| 中间耶尔森氏菌 | |
| 戈氏链球菌 | 模式菌株 |
| 肺炎克雷伯氏菌臭鼻亚种 | |
| 黑曲霉 | |
| 迟缓埃格特菌 | 模式菌株 |
| Lysobacter soli | |
| Caldariomyces fumago | 产氯化物过氧化物酶 |
| 草螺菌 | |
| 纳塔尔链霉菌 | 模式菌株 |
| 绵羊布鲁氏菌 | 人畜共患疾病研究 |
| 肠炎沙门氏菌亚利桑那亚种 | 模式菌株 |
风险提示:丁香通仅作为第三方平台,为商家信息发布提供平台空间。用户咨询产品时请注意保护个人信息及财产安全,合理判断,谨慎选购商品,商家和用户对交易行为负责。对于医疗器械类产品,请先查证核实企业经营资质和医疗器械产品注册证情况。
 文献和实验
文献和实验诱人的食用色素,却可能有害健康?何正祥等 Cell 子刊报道其促进肠炎发生的机制!
Metabolism肠道微生物对肠炎的发生有着关键作用,诱惑红诱导的结肠炎是否需要微生物的参与呢?作者发现在无菌小鼠中不会诱导肠炎的发生,但 16S rRNA 测序分析发现,诱惑红并不会影响肠道微生物组成的变化。这些结果表明,诱惑红诱导的结肠炎依赖于肠道微生物,但并不依赖于其组成的显著变化。图片来源:Cell Metabolism进一步的分析发现,卵形拟杆菌(B.ovatus)和粪肠球菌(E.faecalis)有助于诱惑红诱导的 R23FR 小鼠结肠炎的发生。 图片来源:Cell Metabolism作为一种偶氮
深度解读 Nature 开创性新成果:首次利用噬菌体疗法治疗酒精性肝病
2019 年 11 月 13 日,美国加州大学圣迭戈分校(UCSD)的 Bernd Schnabl 教授科研团队在 Nature 发表题为 《Bacteriophage targeting of gut bacterium attenuates alcoholic liver disease》 的文章,鉴定出可加剧酒精性肝病的关键肠道细菌(粪肠球菌,Enterococcus faecalis)所分泌的细菌毒素,并提供了噬菌体疗法对酒精性肝炎的有效性,为重度酒精性肝炎患者提供了新的治疗策略。酒精
临床病原菌对抗菌药物的抗药性,在不同年龄段的患者中存在差异。引起我国成年人群感染那的病原菌以革兰氏阴性菌为主(66.8%),许多致病菌对常见抗菌药物严重耐药,儿童感染革兰氏阴性菌和阳性菌的比例较接近(52.5%:47.2%),部分细菌耐药有上升趋势。因此,促进抗菌药的合理使用非常重要。 敏感率在70%以上标记为敏感S,耐药率在50%以上标记为耐药 肠球菌属 粪肠球菌对多数抗菌药的耐药率均低于屎肠球菌,但屎肠球菌对氯霉素、米诺四环素的耐药率低于粪肠球菌。对万古










